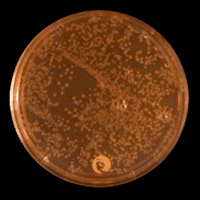

Home
Research Labs
Schildkraut Lab
Schildkraut Lab
Bioluminescence and coelenterazine sulfotransferase
Bioluminescence and coelenterazine sulfotransferase
We have cloned and expressed two full-length cDNAs that encode two distinct Renilla Coel-STs by combining de novo peptide sequencing with transcriptome analysis. These were both shown to convert coelenterazine sulfate to coelenterazine. The sulfotransferase is a member of the Pfam, PF00685. The recombinant form of Coel-ST now makes practicable a very sensitive PAP assay described by Stanley in 1975 and refined further by Anderson in 1978.
Detection of Gaussia luciferase expressed in E. Coli

Pathway for conversion of coelenterazine sulfate to green light via Bioluminescense Resonance Energy Transfer in the soft coral Renilla

